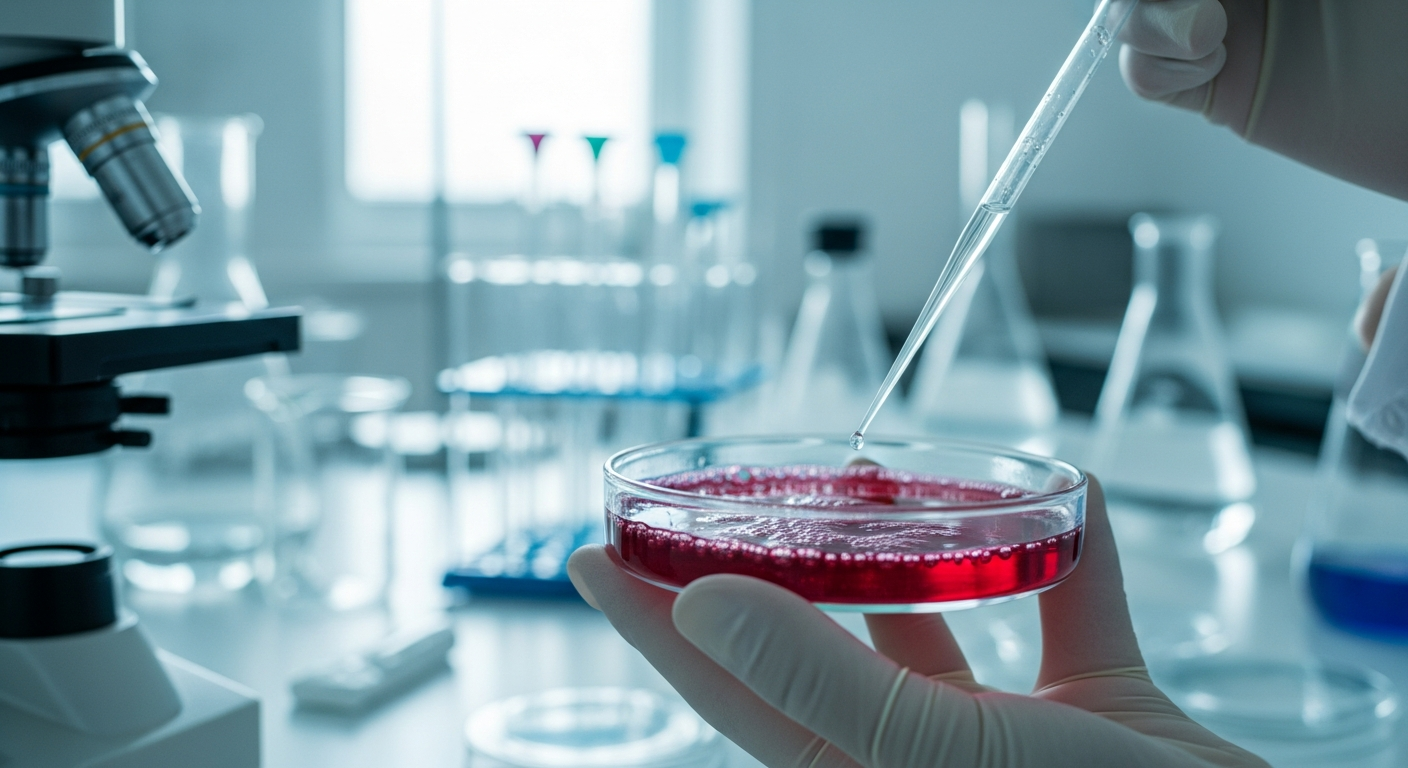

Decoding the Role of Antioxidants in Maintaining Youthful Skin
Antioxidants are compounds that play a significant role in protecting the body's cells from damage caused by free radicals, which are unstable molecules that can harm cellular structures. This cellular protection extends to the skin, where antioxidants help mitigate the visible signs of aging and environmental stress. Understanding how these powerful molecules function can provide valuable insights into maintaining a vibrant and healthy complexion, contributing to overall skin vitality and appearance over time. Their presence in skincare and diet is a key aspect of a comprehensive approach to skin health.
How Do Antioxidants Contribute to Skin Radiance?
Antioxidants are crucial for maintaining skin health and promoting a radiant appearance. They work by neutralizing free radicals, which are byproducts of metabolic processes and environmental factors like UV radiation and pollution. These free radicals can damage skin cells, leading to premature aging, dullness, and a loss of elasticity. By counteracting this oxidative stress, antioxidants help protect collagen and elastin fibers, which are essential for the skin’s structure and firmness. Regular integration of antioxidant-rich skincare products and a balanced diet can enhance the skin’s natural glow and overall vitality.
What Role Does Nutrition Play in Skin Vitality?
Nutrition is fundamental to skin vitality and its ability to repair and rejuvenate itself. A diet rich in antioxidants, vitamins, and minerals provides the building blocks for healthy skin cells and supports their protective functions. Foods such as berries, leafy greens, nuts, and green tea are packed with compounds like Vitamin C, Vitamin E, beta-carotene, and selenium, all of which act as powerful antioxidants. These nutrients help to strengthen the skin’s barrier, improve its resilience against environmental aggressors, and contribute to a more youthful and healthy complexion. Prioritizing nutrient-dense foods is an effective strategy for supporting skin wellness from within.
How Do Hydration and Movement Support Skin and Overall Wellness?
Hydration and regular movement are interconnected elements that significantly impact both skin health and overall wellness. Adequate hydration ensures that skin cells are plump and function optimally, contributing to a smoother texture and a more supple appearance. Dehydrated skin can look dull and emphasize fine lines. Drinking sufficient water throughout the day is vital, as is incorporating hydrating foods. Complementing this, consistent movement and exercise enhance blood circulation, delivering essential nutrients and oxygen to the skin cells while also helping to remove waste products. This improved circulation can lead to a healthier complexion and supports the body’s natural detoxification processes, contributing to a sense of balance and vitality.
What Is the Connection Between Physical Activity and Skin Tone?
Engaging in regular physical activity, often referred to as exercise, has a direct impact on skin tone and elasticity. When you exercise, the increased blood flow nourishes skin cells and carries away waste products, which can contribute to a clearer and more even skin tone. Furthermore, certain types of movement can help maintain the skin’s flexibility and support the underlying muscle structure, which in turn can influence the skin’s appearance. Activities that promote strength and endurance can contribute to a toned physique, and this overall physical conditioning is often reflected in the skin’s firmness and healthy look. A consistent routine of physical activity supports both aesthetic goals and general health.
How Do Self-Care and Balance Support Skin and Overall Well-Being?
Self-care practices and maintaining a balanced lifestyle are integral to holistic well-being, which in turn reflects on skin health. Stress, lack of sleep, and an imbalanced routine can trigger hormonal fluctuations and increase oxidative stress, negatively impacting the skin. Incorporating selfcare activities, such as mindfulness, adequate rest, and stress-reducing techniques, can help mitigate these effects. When the body and mind are in balance, the skin has a better opportunity to repair and regenerate, contributing to a healthy glow. A comprehensive selfcare routine that includes proper skincare, nutrition, hydration, and movement creates an environment where the skin can thrive, promoting overall radiance and sustained vitality.






